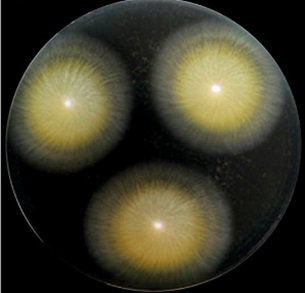

Vědci popsali původce dětských infekcí kůže přenášených morčaty
13. 01. 2021
Lékaři se ve svých ordinacích čím dál častěji setkávají se záněty kůže u dětí, které způsobují morčata. Infekce pocházející od oblíbených domácích mazlíčků se v Evropě včetně Česka rozšiřuje zejména v posledních deseti až patnácti letech. Vědci z Mikrobiologického ústavu AV ČR a Univerzity Karlovy nyní objasnili původce nákaz, a popsali přitom několik nových patogenů. Jejich zjištění může lékařům pomoci k lepšímu určení onemocnění kůže. Výsledky zveřejnil časopis Fungal Diversity.
Dětským toužebným očím je mnohdy těžké odolat, obzvláště před Vánoci. Není divu, že pod stromečkem nejedna ratolest najde vymodleného křečka nebo morče. Radost ale někdy vystřídá překvapení nad nečekanou zdravotní komplikací. Svědčí o tom každoroční nárůst návštěv v ordinacích v povánočním čase.
Nejběžnějším původcem zánětů kůže vyvolaných přenosem ze zvířat na lidi je v posledních letech dermatofyt (plíseň, která napadá kůži) druhu Trichophyton benhamiae. Nejčastěji se objevuje právě u morčat. V početnosti dokonce překonal infekce přenášené z koček a psů.
U morčat zpravidla nemoc nepoznáte, s výjimkou mláďat nebo oslabených jedinců. U člověka, zejména u dětí, se ale projeví docela zřetelnou vyrážkou.

Takto se může u dítěte projevit infekce patogenem morčat Trichophyton benhamiae.
„Patogen tvoří tři hlavní odlišné populace. Dvě jsou severoamerického původu, zatímco třetí, klonálně se šířící, způsobuje epidemii v Evropě. Data však ukazují, že se šíří i do mimoevropského prostoru, například do Japonska, kde je také patrná obliba chovu drobných hlodavců,“ říká vedoucí laboratoře genetiky a metabolismu hub Miroslav Kolařík z Mikrobiologického ústavu AV ČR.
Tři nové druhy patogenů
Vědci zjistili, že už před rokem 2000 vyvolávaly infekce morčat nejen známé patogeny Trichophyton benhamiae, ale také dosud nepopsané druhy rodu Trichophyton. Jedná se sice o blízce příbuzné druhy T. benhamiae, ale přesto jiné. „Popsat nový, klinicky významný houbový patogen je vzácný moment. V této studii se nám podařilo popsat dokonce tři,“ zdůrazňuje Miroslav Kolařík.
Tyto nové sesterské druhy způsobují zhruba pětinu infekcí morčat, králíků a dalších zvířat v Evropě. Dosud byly často nesprávně diagnostikovány právě jako T. benhamiae. Detailnější poznání patogenů pomůže klinickým pracovištím v budoucnu lépe určovat infekci a následnou léčbu.
Kolonie houby Trichophyton benhamiae
Dlouhodobý výzkum kožních problémů
Vědci pokračují v objasňování jevu, proč je epidemická evropská populace tak úspěšná v šíření mezi hostiteli v porovnání s ostatními druhy a populacemi rodiny T. benhamiae. „Podařilo se nám objevit několik látek pravděpodobně zodpovědných za vysokou infekčnost patogenu. Vedle druhů přenášených na člověka z morčat se zaměřujeme na mykózy přenášené z ježků, jejichž obliba mezi chovateli také stoupá,“ dodává mikrobioložka Adéla Čmoková. V té souvislosti narůstají případy lidí nakažených ježčím patogenem T. erinacei, který je pro ježky stejně typický jako T. benhamiae pro morčata.
Mikrobiologové si pochvalují, že se jim díky spolupráci se zahraničními výzkumníky z dalších evropských zemí, Japonska a USA podařilo zasadit výsledky do globálního kontextu. „Věříme, že si práce najde své čtenáře nejen mezi odborníky na taxonomii a populační genetiku, ale také mezi lékaři a širší veřejností. Obsahuje totiž bohatou obrazovou dokumentaci patogenů klinických příznaků infekcí a nabízí nástroje pro diagnostiku a monitoring infekcí v praxi,“ uzavírá vedoucí mezinárodního týmu Vít Hubka z laboratoře genetiky a metabolismu hub Mikrobiologického ústavu AV ČR. Výsledky studie by podle něho mohly vést i k přísnější kontrole chovu zvířat, která jsou častým zdrojem nákazy pro člověka.
Mikrobiologický ústav AV ČR spolupracuje s mnoha klinickými pracovišti dlouhodobě. Současný výzkum infekcí kůže přenášených zvířaty je jednou z linií, jež navazuje na desetiletou epidemiologickou studii mapující dermatomykózy v České republice.
Připravila: Leona Matušková, Divize vnějších vztahů SSČ AV ČR
Foto: Shutterstock, archiv Mikrobiologického ústavu AV ČR
Přečtěte si také
- Reprodukční odysea aneb Jak chytit nejkvalitnější spermii
- Plísně jsou vděčné téma, nikoho nenechají chladným, říká mykolog
- Breberky mě fascinovaly odmala, říká mikrobiolog Michal Kraus
- Učíme se, vybavujeme si a zapomínáme. Co dokáže paměť a jak ji přelstít?
- Nádorové buňky jako zlodějky. Jak posílit imunitní systém, aby na ně vyzrál?
- Nová sloučenina chrání kostní buňky, může pomoci pacientům s cukrovkou
- Růst listů, kořenů, kvetení i rozmnožování aneb Za vším hledej hormon
- Řekni mi to vůní. Pachová komunikace řídí životy zvířat i lidí
- Luční kvítí klíčem k poznání evoluce. Vědci popsali DNA chromozomu Y
- Jak se mozek zotavuje po mrtvici? Odpovědi přináší studie českých vědců